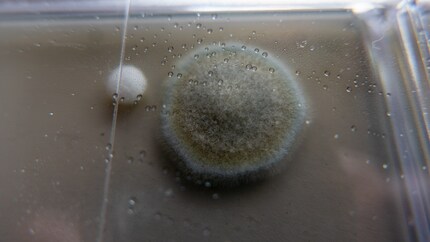
Ma magnifique créature.

Test de produit
Tout pour vomir ou quoi ? La poudre à détacher Pikosch en essai
par Martin Rupf

La moisissure, c’est de la m...oisissure. Comment la vaincre ? Cette question me hante depuis quelques années et je ne suis pas sûr de gagner la bataille de sitôt. Le test rapide de Mellerud devrait fournir de nouveaux indices.
« Est-ce que quelqu’un a un problème de moisissure et veut écrire un article à ce sujet ? » Alors que la question fait irruption dans notre tchat éditorial, mon regard se porte sur ma chambre à coucher : des murs extérieurs froids, de vieilles fenêtres en bois, une humidité chroniquement élevée qui s’infiltre par toutes les fissures depuis le jardin. En automne et en hiver, je ne peux pas essuyer les fenêtres aussi rapidement que la condensation se forme.
Autour des fenêtres et dans les coins, je me suis déjà attaqué aux traces de moisissures. Mais je ne suis pas sûr de maîtriser le problème, je ne sais pas ce qui se cache derrière les armoires et les plinthes. C’est pourquoi je dis : « Ici ! Soupçon de moisissure ! »
À quoi dis-je m’attendre ? Aux premières informations sur la qualité de l’air intérieur. Le test rapide ne promet rien de plus. Il devrait permettre de savoir si ce qui prend vie dans la pièce doit vous inquiéter. Si la réponse est positive, vous pouvez réfléchir à d’autres mesures.
Je me suis entretemps assuré que je pouvais en faire plus que ce que je fais actuellement à titre préventif, et je lis les informations que j’ai reçues sur les paquets de tests. Il s’agit de principes de base que vous devez connaître et suivre à la lettre :
Je n’ai pas grand-chose à me reprocher. À quoi donc ressemble le « sporomètre » après cinq jours ? Voyons les résultats de l’enquête menée par le commissaire Mellerud. Je n’attends pas de preuves incriminantes, mais plutôt des indices.
Écrivain amateur et père de deux enfants, j’aime être en mouvement et avancer en équilibre sur le chemin sinueux de la vie de famille. Je jongle avec plusieurs balles et il m’arrive parfois d’en faire tomber une. Il peut s’agir d’une balle, ou d’une remarque. Ou des deux.
Nos expertes et experts testent les produits et leurs applications, de manière indépendante et neutre.
Tout afficherJe reçois quelques jours plus tard un colis de test de Mellerud. Il contient un agent anti-moisissure sans chlore, censé éliminer les spores, les taches de moisissures et toutes ces choses désagréables. On y trouve toutes sortes d’informations sur le sujet et surtout un test rapide. Je veux qu’il m’indique l’ampleur de mon problème et si je dois agir. Je n’ai pas été aussi excité par un gadget depuis mon dernier numéro d’YPS.
La moisissure peut vous rendre malade. Vous trouverez par exemple des informations générales dans la publication Attention aux moisissures de l’OFSP ou dans le Schimmel-Leitfaden de l’Agence fédérale allemande pour l’environnement. En outre, vous pouvez lire toutes sortes de choses effrayantes sur le net que je ne citerai pas ici. Ces informations sont bien souvent exagérées, comme on peut le lire dans cet article. Il est certain que si elle se propage dans l’appartement, elle doit être éliminée. Il serait également naïf de placer toute sa confiance dans un petit bol en plastique lors de l’analyse et de la recherche des causes.
Sans inspection sur place, par exemple seulement après des mesures effectuées par l’utilisateur lui-même (kits de test rapide de moisissures que vous faites vous-même), une évaluation professionnelle d’une infestation de moisissure n’est fondamentalement pas possible.
Tout d’abord, le test rapide me ramène 25 ans en arrière, durant le cours élémentaire de biologie. Depuis lors, je n’ai plus été confronté avec des boîtes de Petri et les autres objets du même genre. Je commence maintenant une expérience relativement simple avec le « sporomètre ». Pour ce faire, j’ouvre l’emballage stérile et je sors la boîte rectangulaire en plastique avec ses deux zones de test, chacune divisée en quatre sections par un réticule.

On le place dans une pièce et on pousse soigneusement pour l’ouvrir, on ne doit pas la suite plus le toucher. Je m’éloigne sur la pointe des pieds et le laisse ouvert dans la pièce fermée, en suivant les instructions à la lettre, pendant exactement 30 minutes. Je me faufile ensuite à nouveau et les referme doucement, car la moindre brise peut fausser le résultat. Le sporomètre retourne dans sa boîte et va sur l’armoire. Cinq jours plus tard, je saurai ce qui s’est retrouvé sur la surface de test. La moisissure va se développer, former des colonies et, espérons-le, ne pas m’effrayer.

Je me suis préparé au pire lorsque je sors à nouveau le test rapide de son emballage après la période d’incubation. Je m’imagine déjà les masses de colonies de moisissures. La chambre à coucher devient une zone interdite, je me prépare déjà à passer des nuits dans le salon. C’est à ce moment-là que je regarde, et le premier coup d’œil est rassurant. C’est pas si mal. Je dois maintenant compter les colonies de moisissures qui se sont formées sur la surface d’essai : des tas pelucheux de différentes tailles, d’un blanc feutré, poussent allègrement là où les spores correspondantes ont atterri il y a cinq jours. De petites quantités sont normales, mais de trop grandes quantités posent problème.
Je compte jusqu’à cinq. Le nombre de colonies s’avère étonnamment faible et se situe toujours dans la zone verte. Le tableau des lignes directrices ci-joint indique que la charge est inoffensive lorsque le nombre de bactéries ne dépasse pas 10, un peu inquiétante entre 10 et 10 et préoccupante au-delà. Les instructions ne révèlent pas exactement ce que j’y ai fait pousser. Bien que différentes colonies y soient représentées et que je reconnaisse un type, il n’y a pas d’explication. Il n’y a même pas un nom à côté que je pourrais utiliser pour effectuer des recherches sur Google en cas de panique.
Je sais seulement que le résultat me rassure quelque peu : la situation n’est pas aussi grave que ce que je craignais. D’après le test, la concentration de spores dans l’air ne constitue pas un problème. Pour en savoir plus, je pourrais envoyer le sporomètre à un laboratoire pour une analyse qui coûte la modique somme de 84 euros. Je m’en passerai. Je n’ai pas besoin de savoir si les quelques traces de spores sont des Rhizopus oryzae, des Aspergillus ou des Scopulariopsis. Si la surface d’essai avait été jonchée de colonies, j’aurais préféré une évaluation sur place plutôt que de commander une analyse microbiologique avec un rapport de laboratoire sur le potentiel de danger de cette base.

Je dois néanmoins faire quelque chose contre la moisissure. D’une part, mettre fin à la colonisation du sporomètre , comme me le disent les instructions. D’autre part, j’utilise le liquide sans chlore pour prendre soin de mes cadres de fenêtre. Le dissolvant, adapté aux zones sensibles et aux surfaces absorbantes, est censé fonctionner sur le bois et le papier teint, dans les chambres à coucher ou les chambres d’enfants tout en se montrant inoffensif. Il s’applique par pulvérisation, comme tous les produits de ce type, et doit agir pendant au moins 15 minutes. En cas de forte infestation, parfois toute la nuit. Essuyez ensuite le résidu avec un chiffon ou une éponge et des mains gantées. Un adieu serait agréable, mais la prochaine chasse aux moisissures ne manquera pas d’arriver, c’est aussi certain que l’automne humide et froid à Zurich. Que penser du test rapide ? Il permet au moins de se rassurer un peu.
Qui achètera les 20 produits au prix le plus bas ? Premier arrivé, premier servi.






Siemens EQ700 integral TQ717D03